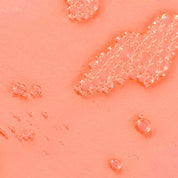

Olio da bagno al fieno Susanne Kaufmann | Edizione limitata
Susanne Kaufmann Olio da bagno al fieno in edizione limitata
Un bagno alpino di calma e nutrimento profondo
L' olio da bagno ai fiori di fieno di
Realizzata con estratto di fieno ottenuto a mano da prati naturali e non trattati, questa miscela offre un momento di benessere olistico. La sua texture si trasforma a contatto con l'acqua in un velo lattiginoso che rilassa i muscoli, attiva la circolazione e lascia la pelle setosa e nutrita.
L'olio di colza e l'olio di mandorle dolci forniscono un'idratazione di lunga durata, mentre gli oli essenziali di abete, lavanda, timo e rosmarino rilasciano una fragranza erbacea che calma i sensi e favorisce il riposo. La presenza di astaxantina , un potente antiossidante di origine naturale, conferisce alla formula la sua caratteristica tonalità rossastra e aiuta a lenire e rivitalizzare la pelle.
Progettata per trasformare il bagno in un vero e proprio rituale di cura di sé, questa edizione limitata è un invito a fermarsi e a riconnettersi con se stessi. Un gesto semplice che riequilibra, idrata e conforta anche nelle giornate invernali più fredde
- Estratto di fieno: Riconosciuto per i suoi effetti lenitivi e per la sua capacità di promuovere il benessere generale. Proveniente dai prati alpini dell'Austria, conserva tutte le sue proprietà grazie a un'estrazione artigianale e delicata
- Astaxantina: Antiossidante naturale derivato dalle alghe, aggiunge luminosità e aiuta a levigare la pelle
- Olio di mandorle dolci: migliora l'elasticità e lascia la pelle più liscia ed elastica
- L'olio di abete rosso e rosmarino: stimola la circolazione e dona una sensazione di freschezza e rinnovamento
Modo d'uso
Spedizioni
Le spedizioni in Italia sono gratuite per ordini superiori a 70€. Se l'importo è inferiore, il costo della spedizione è di 9€.
Il costo della spedizione viene calcolato automaticamente al completare le informazioni di spedizione. A seconda della tua ubicazione e del valore totale dell'ordine, il costo può variare.
Resi
Una volta ricevuto il tuo ordine, hai 30 giorni dalla conferma dello stesso per richiedere un reso.
Importante:
- I prodotti devono essere in perfetto stato, non aperti, con il loro imballaggio originale e tutti i loro accessori.
Tempi di Consegna
- Italia: tra 2 e 10 giorni lavorativi.
-
Esempio: se effettui un ordine un venerdì dopo le 14:00, questo verrà processato il lunedì successivo e lo riceverai a partire dal martedì.
Altri Mercati
Spagna e Portogallo
- Le spedizioni alla Spagna peninsulare e Isole Baleari sono gratuite.
- Le spedizioni al Portogallo Continentale sono anche gratuite.
- Le spedizioni alle Canarie, Ceuta e Melilla sono gratuite se l'ordine supera i 70€. Per ordini inferiori, il costo della spedizione è di 30€.
Europa
- Le spedizioni a Germania e Olanda sono gratuite per ordini superiori a 70€.Se l'ordine è inferiore a questa quantità, il costo di spedizione è di 9€.
Tempi di Consegna
- Spagna peninsulare e Portogallo Continentale: tra 1 e 3 giorni lavorativi.
- Isole Baleari: tra 2 e 4 giorni lavorativi.
- Canarie, Ceuta e Melilla: consegna in 7 giorni lavorativi, senza contare le procedure doganali.